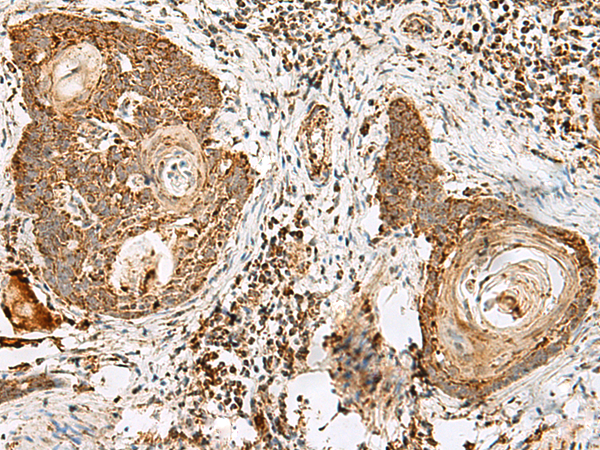

宿 主: Rabbit
反應種屬: Human
相關類別: 一抗
克隆類型: rabbit polyclonal
技術規格
|
Background: |
This gene encodes a member of the CD2 subfamily of immunoglobulin-like receptors which includes SLAM (signaling lymphocyte activation molecules) proteins. The encoded protein is found on the surface of lymphocytes and other immune cells, dendritic cells and endothelial cells, and participates in activation and differentiation pathways in these cells. The encoded protein does not have a transmembrane domain, however, but is held at the cell surface by a GPI anchor via a C-terminal domain which maybe cleaved to yield a soluble form of the receptor. Multiple transcript variants encoding different isoforms have been found for this gene. |
|
Applications: |
ELISA, WB, IHC |
|
Name of antibody: |
CD48 |
|
Immunogen: |
Fusion protein of human CD48 |
|
Full name: |
CD48 molecule |
|
Synonyms: |
BCM1; BLAST; hCD48; mCD48; BLAST1; SLAMF2; MEM-102 |
|
SwissProt: |
P09326 |
|
ELISA Recommended dilution: |
5000-10000 |
|
IHC positive control: |
Human esophagus cancer |
|
IHC Recommend dilution: |
40-200 |
|
WB Predicted band size: |
28 kDa |
|
WB Positive control: |
Raji, Jurkat, K562 and 231 cell, Human kidney tissue lysates |
|
WB Recommended dilution: |
500-2000 |

購物車
購物車 幫助
幫助
 021-54845833/15800441009
021-54845833/15800441009
